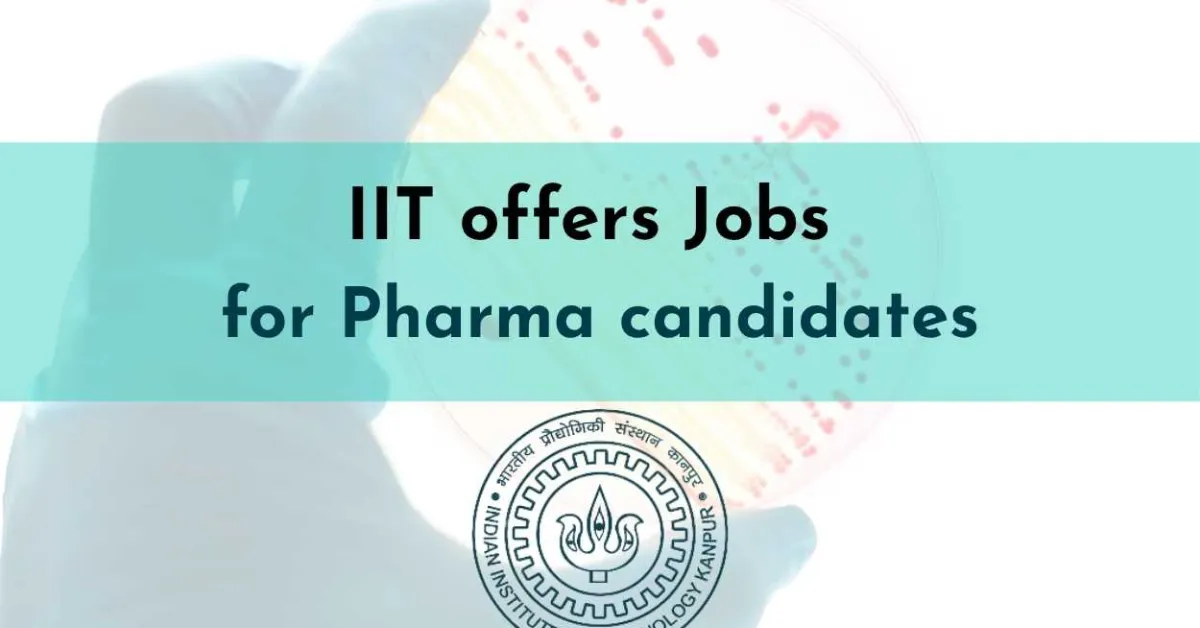
IIT offers Jobs for Pharma candidates

Applications are invited from Indian citizens for filling up the following post of Project Technical Support- II under project title “Next Generation Metallodrugs : a Potent Alternative to FDA Approved Antibiotics for treating Acinetobacter Baumannii Ventilator- Associated Pneumonia” sanctioned by ICMR Investigator Initiated Extramural Research Grant- Small Grant, Department of Chemistry, IIT Kanpur.
Post : Project Technical Support - II
Project Title : “Next Generation Metallodrugs: a Potent Alternative to FDA Approved Antibiotics for treating Acinetobacter Baumannii Ventilator- Associated Pneumonia”
No. of position : 01
Duration : The appointment will be for one year only, which shall be extended upon satisfactory performance
Minimum qualification : B.Tech/B.Sc./B.Pharm/M.Tech/M. S (Pharm)/M.Sc. Equivalent with minimum 60% marks in degree
Desirable qualifications : Bachelor’s degree (B.Tech/B.Sc.) from a recognized institution
Candidates with a background in engineering/science with at last 1.5 years of experience in laboratory-based research environments will be preferred.
Job Description :
1. Maintaining lab inventory of chemicals, glassware, and safety compliance.
2. Assisting with documentation, project-related record keeping, and sample labeling/tracking for downstream testing. Their role is essential to maintain reproducibility in compound synthesis and ensure seamless integration with biological evaluation.
3. Managing sample logs and assisting with routine sterilization, media prep, and waste disposal. Their involvement ensures high-throughput and standardized antimicrobial testing crucial for efficacy assessment.
4. Project Technical Support – II will operate and maintain analytical instrumentation and coordinate in vivo study logistics.
5. Assisting in conducting, monitoring and co-ordinating the activities of the project.
6. Assisting in file/administrative file processing.
7. Any other duty assigned by the PO.
Emoluments : Rs. 24,000/- per month (consolidated)
Age limit : Not more than 35 years as of the date of advertisement with relaxation to SC/ST/OBC/Female candidates as per Govt. of India norms.
Terms and conditions
1. The above position is purely contractual and initially for 1 year.
2. The engagement would be purely on a contractual basis and co-terminus with the project and no claim for continuance of regular appointment will be entertained.
3. No TA/DA will be paid for attending the interview.
4. Canvassing in any form will disqualify the candidature.
How to apply?
Candidates should apply with their CV and Educational certificates, and experience certificates to the following email ID: ritika7gautam@gmail.com. The email should have the title “Application for the post of Project Technical Support- II” on or before 01-04-2026 (Last date of receipt of application). The date of the interview will be intimated to the shortlisted candidates by email.
Date of the Interview : The shortlisted candidates will be informed by email about the interview date and time.
See All Ph.D Alerts B.Pharm Alerts D.Pharm Alerts Kanpur Alerts
See All Other Jobs in our Database
Subscribe to Pharmatutor Job Alerts by Email